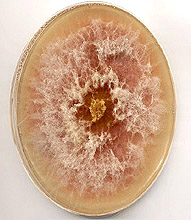

Kevin McCluskey
Curator FGSC
Research Assistant Professor
Department of Microbiology
University of Kansas Medical Center
Kansas City, KS 66160
Email:kmcclusk@kumc.edu
McCluskey, K. 2003. Plant Pathology Related Culture Collection Resources. APSnet Features. Online. doi:10.1094/APSnetFeature-2003-1203.
Introduction
Microbial culture collections provide a wealth of materials and information that can accelerate the progress of research in the biological sciences. Many organizations exist to organize and promote use of culture collections, and the increasing availability of online electronic database information makes access to these collections much easier. Plant pathogenic fungi, bacteria and viruses are available from collections in the United States and around the world. Molecular genetic resources for working on these organisms are available from select collections in addition to their main resources, as are identification services and special restricted or patent depository services. A collection dedicated to plant pathogens, however, does not exist. Most collections have a specific focus, and the long term preservation of the diversity of phytopathogenic microbial germplasm is one area that is generally overlooked. Resources have certainly been lost over the years, and this process is continuing. For example, collections of plant pathogens have often been generated and maintained by individual researchers, and when those individuals retire or change their research emphasis the collections may be neglected or discarded. To gain a better understanding of the context of this problem, we will explore funding opportunities for collections, the variety of collections in existence, trends in organization, and finally look at a specific example of how one collection has grown with its community.
Support
The National Science Foundation has two programs that support living collections, the Living Stock Collection program and the Biological Research Collections program. The former emphasizes long-term support for collections while the latter emphasize relatively short-term grants to make changes to collections. Grants from the Living Stock Collection program often have periods of up to five years, while grants from the Biological Research Collections program do not exceed 3 years. Examples of collections supported include collections of Drospohila, Bacillus, and Algae at the University of Texas Austin, Chlamydomonas at Duke University, Arabidopsis at The Ohio State University, and the ATCC Bacteria, Archaea, and Bacteriophage collections.
| |
 |
The National Institutes of Health provides support for long-term collections via their National Center for Research Resources (NCRR). They support the Saccharomyces Genome Database as well as murine, swine, zebrafish and clinical specimen collections. The NCRR was formed in 1990 by the merger of the Division of Research Resources and the Division of Research Services. The mission of the NCRR is to support biomedical research resources, with the ultimate aim of improving health.
|

|
|
The US Department of Agriculture has an extensive system of germplasm conservation which operates under the banner of the Agricultural Research Service. The main branches of this program are the National Plant Germplasm System (NPGS), the National Animal Germplasm Program (NAGP), the National Microbial Germplasm Program (NMGP), and the National Invertebrate Germplasm Program (NIGP). The NPGS has 454,878 accessions from 10,348 species in 34 facilities. The NMGP consists of the NRRL repository at the NCAUR and the National Rhizobium Germplasm Resource Center.
Additional projects operate under the national program Plant, Microbial, and Insect Genetic Resources. This program has as its mission “To safeguard and utilize plant, microbial, and insect germplasm (genetic raw material), associated genetic and genomic databases, and bioinformatic tools to ensure an abundant, safe, and inexpensive supply of food, feed, fiber, ornamentals, and industrial products for the United States and other nations”.
Collection Overview
The most extensive living culture collection in the United States is the ATCC, which is both a type collection and a patent collection. It is additionally a global bioresource center, as defined by the Organization for Economic Co-operation and Development (2001). The ATCC holds plant pathology related resources in a variety of categories including plant tissue culture and seeds, fungi, bacteria and viruses. The plant collection consists largely of agricultural specimens and is rather small in size. Their bacterial collection is more extensive, containing 18,000 strains from 750 genera. Among these are 188 Erwinia strains, 1,241 Pseudomonas strains (105 P. syringae), 165 Rhizobium strains and 127 Agrobacterium strains. Among their viral holdings are 134 tobacco viruses including 58 Tobacco mosaic virus isolates. Other isolates include type specimens for viruses from Agropyron mosaic potyvirus to Zucchini yellow mosaic virus. They also hold select anti-sera for working with plant viruses, and they hold a small number of phytoplasma specimens. The ATCC encourages deposits with the caveat that not all specimens will be accessioned into the collection. They emphasize breadth and not depth in any one particular area. The ATCC has affiliates around the world and is supported by user fees as well as by grants from the NSF
ATCC Plant Pathology related resources
| Category |
Resource |
Diversity |
| Plant Materials |
75 plant cell cultures and over 400 seed cultivars |
Largely agricultural emphasis |
| Fungi |
27,000 strains |
1,500 genera |
| Bacteria |
18,000 strains |
750 genera |
| Viruses |
over 1000 isolates |
700 viruses |
| Virus antisera |
800 antisera |
|
The USDA houses an extensive collection at the National Center for Agricultural Utilization Research (NCAUR) in Peoria Illinois. The collection is housed within the Microbial Genomic and Bioprocessing Research Unit, and they have both a research and repository mission, including being a Patent Culture Collection under the provisions of the Budapest Treaty. Since this collection was originally designed to serve the needs of the USDA, they have limits on distribution of cultures. They hold filamentous fungi in 20 genera and over 400 species. Included among these are over 200 Penicillium isolates and over 600 Aspergillus isolates. Yeast in 57 genera and 431 species complete their fungal holdings. There are over 600 Saccharomyces isolates in the yeast collection. Their prokaryotic collection includes isolates in nearly 200 genera. Among these are 77 Pseudomonas isolates, 72 Escherichia isolates and 64 Rhizobium isolates. Information about this collection is available online.
The UDSA also supports specialized collections including the Nematode collection at the National Soybean Pathogen Collection Center.
This collection was established very recently and includes nematode, fungal and oomycete isolates. The USDA Nematode Collection is comprised of over 36,000 slides and vials, and they have nematodes from around the world. These however, are not living cultures and are most relevant to physical taxonomy.
The ARS Collection of Entomopathogenic Fungi, which began as Dr. Richard Soper's collection at Maine, rounds out the USDA Microbial Germplasm Program. It is now housed at Cornell University where there are 6,400 strains in the collection.
|
Fusarium graminearum FGSC #9075. The genome of this strain was sequenced at the Whitehead Institute.
|
|
The Fusarium community has a specialized collection that has grown out of a personal research collection. The Fusarium Research Center at Penn State houses over 17,000 Fusarium isolates from around the world. This collection was nurtured for many years by Dr. Paul Nelson. They offer online taxonomic databases and workshops on Fusarium taxonomy and can carry out physical or molecular identifications. Other isolates of Fusarium are held at the USDA NRRL repository and at the FGSC.
The NSF supported International Culture Collection of (Vesicular) Arbuscular Mycorrhizal Fungi houses over 1,000 cultures of mycorrhizal fungi at the West Virginia University. They have isolates from seven genera and over 30 species which are listed online. Their web-site includes descriptions of mycorrhizal fungi as well as methods for working with these fungi.
The Bacillus Genetic Stock Center houses nearly 1,000 mutants of B. subtilis as well as hundreds of isolates of other Bacillus species and other related genera. They also hold lysogens and lytic phage stocks for several Bacillus species. They are located at the Ohio State University and are available online.
Other collections that offer phytopathogens include the CBS in the Netherlands, the DSMZ in Germany, the Belgian Coordinated Collections of Micro-organisms, the Collection Francaise des Bacteries Phytopathogenes, and the International Collection of Micro-organisms in New Zealand. Limitations to using these materials include difficulties in shipping pathogens, especially genetically engineered pathogens, internationally and, in some instances, Material Transfer Agreements.
Globally, the culture collection community is represented by the World Federation of Culture Collections. The WFCC web-site has become a clearing house for information on resources around the world. The WFCC operates under the umbrella of the International Union of Biological Sciences. In the United States, the United States Federation for Culture Collections promotes the interests of culture collections. Both the WFCC and the USFCC publish newsletters which can be viewed online or obtained in print format.
Internet sites listing culture collections
There is a general movement towards consolidation of information about collections in central databases. The Microbial Germplasm Database was an early effort to this end, although it has not been updated in many years. In general, the move toward consolidation of databases has not led to a consolidation of the biological materials described. There are several reasons for this, not the least of which is that the funding for the collections is often linked to their location. However, information about physical resources is easier to obtain even while shipping and permitting regulations may make obtaining the biological materials more difficult.
|

|
|
Of special interest to plant pathologists is the Fungal Genetics Stock Center (FGSC), presently at the University of Kansas Medical Center (KUMC). The FGSC houses a diverse collection of resources for studying plant pathogenic fungi. Among these resources are fungal strains, cloned genes, cloning vectors and gene libraries. Despite their location in a research medical center, their mission does not include maintaining clinical pathogens which are more readily obtained from the ATCC or from the University of Alberta microfungus collection in Canada.
The FGSC was established in 1960 at Dartmouth College in New Hampshire to hold genetically characterized strains of Neurospora and Aspergillus. The collection was moved to Humboldt State University, in California, when the director, Dr. R. Barratt, became Dean of Life Sciences there. In 1985 Dr. Barratt retired and the FGSC moved to KUMC where Dr. J. Kinsey took over the directorship. Dr. Kinsey has guided the FGSC through its expansion to include both strains and molecular resources of value to both the Fungal Genetics and Plant Pathology communities. He will retire in 2004, and the FGSC will re-locate again to the University of Missouri, Kansas City where Dr. M. Plamann will be the new director. While the FGSC has had a peripatetic past, the collection has remained intact and has grown over the years. The present collection is comprised of over 16,000 strains of Neurospora, Aspergillus, Magnaporthe, Fusarium and Schizophyllum. While the original mission of the FGSC was to hold Neurospora strains, recent additions to the collection make it of increased value to plant pathologists. Among these additions are Fusarium VCG and mating type tester strains, RFLP populations for Fusarium and Magnaporthe, and several hundred Schizophyllum strains.
|
 Neurospora crassa FGSC# 987. The genome of this wild-type strain was sequenced at WICGR.
|
|
The FGSC has expanded to include molecular genetic tools and has a broad collection of relevance to the plant pathology community. The holdings range from RFLP probes for Fusarium and Magnaporthe to cloning vectors and cloned genes. The number of gene libraries in the FGSC collection has grown dramatically in the last year with the addition of ordered BAC and fosmid libraries from the Whitehead Institute Center for Genome Research. These libraries form part of the Fungal Genome Initiative which includes such fungi as Neurospora, Aspergillus, Magnaporthe, Fusarium, Ustilago and Coprinus. In addition to these ordered libraries, from which individual clones or groups of clones are available, the FGSC distributes cDNA and genomic libraries for a number of these fungi. Presently such libraries are available for Neurospora, Aspergillus, Fusarium, Magnaporthe, and Coprinus.
Molecular Resources at the FGSC
| Genera |
Fungal Strains |
Molecular and genome tools |
| Neurospora |
12,000 |
cDNA and genomic libraries, cosmid libraries used at WICGR |
| Aspergillus |
2,200 |
cDNA and genomic libraries, fosmid library used at WICGR |
| Magnaporthe |
>19,000 |
fosmid and BAC libraries used at WICGR, RFLP probe kit |
| Fusarium |
366 |
cDNA and genomic libraries, BAC library used at WICGR, RFLP probe kit |
Coprinus or Schizophyllum |
250 |
cDNA and genomic libraries |
| Other |
|
cloning vectors and probes |
The FGSC also publishes the Fungal Genetics Newsletter, a peer reviewed journal available in print and electronic format. The FGN has been available online since 1993 and has recently posted back-issues, making it one of the most comprehensive online resources for fungal genetics.
While many collections of relevance to plant pathology do exist, there is a need for a comprehensive repository of plant pathogens for the long-term preservation of materials used in plant pathology research. Requiring deposition of materials to such a central repository as a condition of publication would guarantee that important research could be replicated and validated. Research with Neurospora and Aspergillus has advanced at a hastened pace because of the wide availability of genetic tools and characterized strains. The same sort of benefit would accrue to plant-pathological researchers if isolates were readily available. While the ATCC does provide a place to deposit type strains, they do not emphasize depth in any particular area and do not have a mandate to serve the plant pathology community. A specific repository, dedicated to preserving and distributing plant pathogenic organisms would be a valuable tool advancing the goals of plant protection for the US and the world.
Selected References
OECD. 2001. Biological Resource Centres: Underpinning the Future of Life Sciences and Biotechnology. Organisation for Economic Co-operation and Development (ISBN 9264186905).
Euzeby, J. P. 1997. List of bacterial names with standing in nomenclature: A folder available on the Internet. Int. J. Syst. Bacteriol. 47:590-592.
Kothera, R. T., Keinath, A. P., Dean, R. A., and Farnham, M. W. 2003 AFLP analysis of a worldwide collection of Didymella bryoniae. Mycol. Res. 107:297-304.
Jong, C. S., and Birmingham, J. M. 1992. Culture collections: Sources and management of Aspergillus cultures for biotechnology. In: Aspergillus, Biology and Industrial Applications. J. W. Bennett and M. A. Klich, eds. Butterworth-Heinemann, Boston
McCluskey, K. 2003. The Fungal Genetics Stock Center: From molds to molecules. Adv. Appl. Microbiol. 52:245-62.
McCluskey, K. 2003. Fungal germplasm and databases. Pages 295-310 in: Applied Mycology & Biotechnology: Fungal Genomics. G. G. Khachatourians, D. K. Arora, eds. San Diego Technical Books, Inc. San Diego, CA.